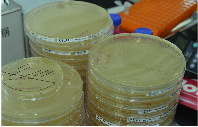

生物信息

數(shù)據(jù)管理

智能流程

大數(shù)據(jù)


通過生物信息學對DNA和蛋白質(zhì)序列進行分析
累積了大量酶定向進化項目數(shù)據(jù),為實驗提供指引









通過生物信息學對DNA和蛋白質(zhì)序列進行分析
累積了大量酶定向進化項目數(shù)據(jù),為實驗提供指引

相較于傳統(tǒng)實驗效率大幅度提升
實現(xiàn)標準化、流程化,實驗結(jié)果精準可靠







酶制備規(guī)模化,酶催化應(yīng)用工藝實現(xiàn)產(chǎn)業(yè)化
控制成本,保證質(zhì)量,提高產(chǎn)品競爭力